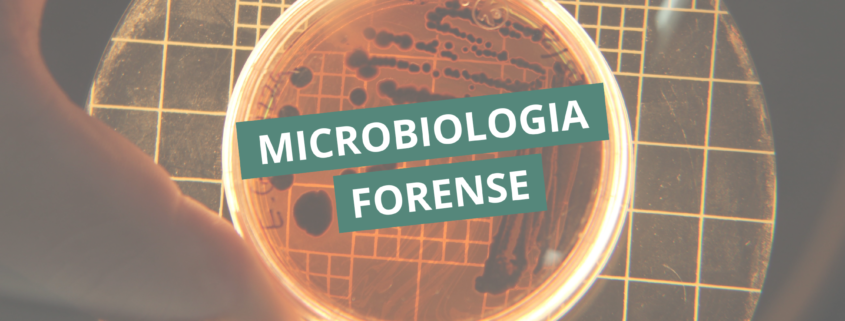

Microbiologia forense
A interface entre ciência e justiça tem se expandido de forma significativa nas últimas décadas, impulsionada pelo avanço das técnicas laboratoriais e pela crescente complexidade das investigações criminais. Nesse cenário, a microbiologia forense emerge como um campo promissor, capaz de utilizar microrganismos como ferramentas para reconstrução de eventos, identificação de fontes de contaminação e até mesmo associação de indivíduos a cenas específicas.
Diferente das abordagens mais tradicionais da perícia, que frequentemente se concentram em impressões digitais, DNA humano ou análise toxicológica, a microbiologia forense explora um universo invisível, mas altamente informativo: a diversidade microbiana presente em superfícies, objetos, ambientes e no próprio corpo humano.
Microorganismos como evidência científica
Os microrganismos estão presentes em praticamente todos os ambientes e superfícies, formando comunidades complexas conhecidas como microbiotas. Essas comunidades não são aleatórias: sua composição varia de acordo com fatores como localização geográfica, condições ambientais, interação humana e tempo de exposição.
Essa variabilidade permite que assinaturas microbianas sejam utilizadas como marcadores forenses. Em uma cena investigada, por exemplo, a análise microbiológica pode contribuir para:
- Diferenciar ambientes e superfícies
- Estimar tempo de deposição de evidências
- Associar objetos a determinados locais
- Inferir contato entre indivíduos e ambientes
A chamada “impressão digital microbiana” surge, portanto, como uma ferramenta complementar à genética forense clássica, com potencial para ampliar a robustez das análises periciais.
Aplicações práticas no contexto forense
A microbiologia forense possui aplicações diversas, que vão além da simples identificação de microrganismos. Entre as principais abordagens laboratoriais, destacam-se:
Estimativa do intervalo pós-morte
Após a morte, o corpo humano sofre alterações previsíveis, incluindo mudanças na composição da microbiota. O estudo dessas alterações, conhecido como thanatomicrobiome, permite estimar o intervalo pós-morte com base na sucessão microbiana.
Diferentes grupos de bactérias e fungos proliferam em momentos distintos da decomposição, criando padrões que podem ser analisados por técnicas moleculares.
Rastreamento de origem geográfica
Ambientes distintos apresentam perfis microbianos característicos. A análise de amostras coletadas em objetos, roupas ou superfícies pode indicar a origem geográfica ou ambiental de determinado material.
Essa abordagem tem sido explorada, por exemplo, na investigação de deslocamento de evidências entre locais diferentes.
Investigação de surtos e eventos intencionais
A microbiologia também desempenha papel relevante na investigação de surtos infecciosos suspeitos, incluindo aqueles potencialmente associados a ações deliberadas.
A caracterização molecular de cepas microbianas permite identificar fontes de infecção, rotas de transmissão e possíveis manipulações laboratoriais.
Técnicas laboratoriais utilizadas
O avanço da microbiologia forense está diretamente relacionado à incorporação de metodologias modernas, especialmente aquelas baseadas em biologia molecular.
Entre as principais técnicas empregadas, destacam-se:
- Reação em cadeia da polimerase (PCR): amplificação de material genético microbiano para identificação específica
- Sequenciamento de nova geração (NGS): análise abrangente de comunidades microbianas
- Metagenômica: estudo do material genético total presente em uma amostra
- Cultura microbiológica: isolamento de microrganismos viáveis em culture media
- Espectrometria de massas (ex.: MALDI-TOF): identificação rápida baseada em perfis proteicos
Essas abordagens permitem não apenas identificar microrganismos, mas também compreender a estrutura e dinâmica das comunidades microbianas em diferentes contextos.
Desafios e limitações
Apesar do potencial promissor, a microbiologia forense ainda enfrenta desafios importantes para sua consolidação como ferramenta pericial de rotina.
Um dos principais pontos críticos é a padronização de métodos. A alta variabilidade das comunidades microbianas, influenciada por múltiplos fatores ambientais, pode dificultar a reprodutibilidade dos resultados.
Além disso, a interpretação dos dados exige cautela, especialmente em análises baseadas em metagenômica, que geram grandes volumes de informação e demandam robustez estatística.
Outro aspecto relevante é o risco de contaminação, tanto durante a coleta quanto no processamento laboratorial. Em um contexto forense, pequenas falhas podem comprometer significativamente a confiabilidade da evidência.
Perspectivas futuras
Com o avanço contínuo das tecnologias de sequenciamento e bioinformática, a tendência é que a microbiologia forense se torne cada vez mais integrada às investigações criminais.
A construção de bancos de dados microbiológicos, aliados a modelos computacionais preditivos, pode ampliar a capacidade de comparação entre amostras e fortalecer a interpretação dos resultados.
Além disso, a integração com outras áreas, como genética forense, toxicologia e química analítica, tende a consolidar abordagens multidisciplinares mais robustas.
A microbiologia forense representa uma expansão significativa das possibilidades analíticas no contexto da perícia criminal. Ao explorar a diversidade microbiana como fonte de informação, esse campo amplia a capacidade de reconstrução de eventos e oferece novas perspectivas para a produção de evidências científicas.
Ainda que desafios metodológicos e interpretativos persistam, o avanço das técnicas laboratoriais e o aprofundamento do conhecimento sobre comunidades microbianas indicam um caminho promissor para sua aplicação cada vez mais consistente na prática pericial.
Na Pós-graduação em Ciências Forenses e Perícia Criminal da Cursau Educação, você aprende a interpretar evidências microbiológicas na prática, conectando análises laboratoriais à tomada de decisão no contexto pericial.